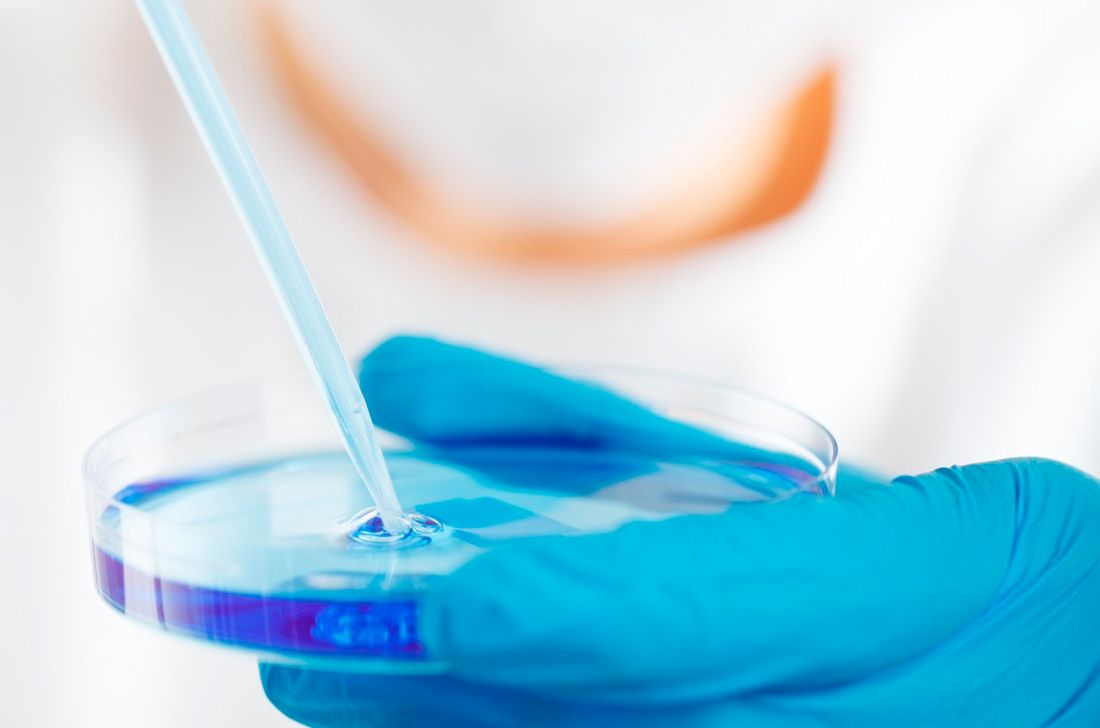
laboratorio

Impacto del coronavirus en el mercado global de estaciones de trabajo de laboratorio dental – Informe global de la industria, 2026
Escrito por XPinyol en . Publicado en Sin categoría.
Análisis del mercado global Estaciones de trabajo de laboratorio dental en términos de tamaño, participación, tendencias de la industria, descripción general de la empresa, desarrollo, crecimiento y pronóstico hasta 2026
Market Research Store ha actualizado y agregado recientemente el Informe de mercado global Estaciones de trabajo de laboratorio dental. Este informe proporciona una amplia cobertura del mercado con análisis en profundidad, tablas, figuras y estadísticas que ayudarán a los actores de la industria a tomar decisiones estratégicas.
El tamaño del mercado global Estaciones de trabajo de laboratorio dental en términos de valor [y volumen] se ha incluido en el expediente junto con otros aspectos importantes como la segmentación del mercado, el análisis regional y los perfiles de la empresa de los actores del mercado involucrados en el negocio. Otra información de mercado que está disponible en el informe incluye factores de crecimiento del mercado, limitaciones, oportunidades, desafíos, canales de venta, distribuidores y mucho más.
Haga clic aquí para acceder al informe PDF de muestra gratuito (que incluye el análisis de impacto de COVID-19, TOC completo, tablas y figuras): http://www.marketresearchstore.com/report/global-dental-laboratory-workstations-market-report-2018-industry-309523#RequestSample
Lista de los principales jugadores clave / fabricantes líderes del mercado Estaciones de trabajo de laboratorio dental: MULTY-DENT, DentalEZ Group, Lista International Corp., KaVo Dental, SARATOGA, ASTRA MOBILI METALLICI, ZILFOR, ERIO, LOC Scientific, Sinol dental, KPF Dental, Iride International, REITEL Feinwerktechnik GmbH, CATO SRL, Dental Art
Según el informe, el mercado global Estaciones de trabajo de laboratorio dental registró un valor de USD XX millones en 2019 y anticipa registrar USD XX millones para fines de 2026. La CAGR esperada para el mercado Estaciones de trabajo de laboratorio dental es del XX%.
La segmentación del mercado que se incluye en el informe:
Mercado global Estaciones de trabajo de laboratorio dental: por análisis de producto
Mesas dobles, Mesas individuales
Mercado global Estaciones de trabajo de laboratorio dental: por análisis de Applicaton
Clínica, Hospital
Lea el índice detallado del estudio de investigación completo en @ http://www.marketresearchstore.com/report/global-dental-laboratory-workstations-market-report-2018-industry-309523
Mercado global Estaciones de trabajo de laboratorio dental: por análisis regional
• Norteamérica
• Asia Pacífico
• America latina
• Europa
• Medio Oriente y África
El informe de análisis de mercado Estaciones de trabajo de laboratorio dental incluye soluciones para lo siguiente:
1. ¿Qué tecnología está en tendencia actualmente en el mercado Estaciones de trabajo de laboratorio dental? ¿Qué desarrollos adicionales se esperan en el período de pronóstico? ¿Qué tendencias han dado lugar a estos desarrollos?
2. ¿Quiénes son los jugadores clave mundiales que ocupan actualmente la primera posición en el mercado Estaciones de trabajo de laboratorio dental? ¿Cuáles son sus estrategias comerciales, sus desarrollos de productos y datos de contacto?
3. ¿Cuál fue el estado del mercado global? ¿Cuáles fueron la capacidad, el valor de producción, el costo y las ganancias del mercado Estaciones de trabajo de laboratorio dental?
4. ¿Cuál es el estado actual del mercado de la industria? ¿Cuál es la competencia del mercado en términos de empresas y regiones?
5. ¿Cuáles son las proyecciones previstas para el mercado Estaciones de trabajo de laboratorio dental en términos de capacidad, producción y valor de producción? ¿Cuál será la evaluación de costos y ganancias?
6. ¿Qué es el análisis de la cadena de mercado Estaciones de trabajo de laboratorio dental por materias primas ascendentes y la industria descendente?
7. ¿Cuál es el impacto económico en la industria Estaciones de trabajo de laboratorio dental debido a COVID-19?
8. ¿Cuáles son las dinámicas del mercado Estaciones de trabajo de laboratorio dental? ¿Cuáles son los desafíos y las oportunidades?
Pregunte más o comparta preguntas antes de la compra en este informe: http://www.marketresearchstore.com/report/global-dental-laboratory-workstations-market-report-2018-industry-309523#InquiryForBuying
Fuente: Tecnoaliment Portal [/fusion_text][/fullwidth]